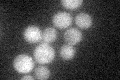
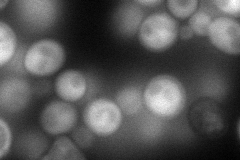
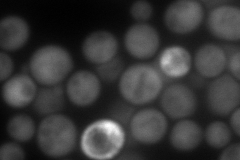
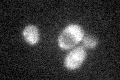

View description
Thymidylate and uridylate kinase, functions in de novo biosynthesis of pyrimidine deoxyribonucleotides; converts dTMP to dTDP and dUMP to dUTP; essential for mitotic and meiotic DNA replication; homologous to S. pombe Tmp1p
Localization:
Intensity:
Fold change:
Significance:
-
C’ GFP library in SD
cytosol25.97 -
N' NOP1pr-GFP in SD
cytosol124.951 -
N' TEF2pr-mCherry in SD
cytosol214.211 -
N' NATIVEpr-GFP in SD

cytosol35.294 -
N' TEF2pr-VC and Cyto-VN in SD

cytosol61.5672 -
C’ GFP library in SD+DTT

cytosol25.570.98No -
C’ GFP library in SD+H2O2
cytosol21.780.83No -
C’ GFP library in Starvation Media

cytosol19.930.76No -
C’ GFP library on the background of Pup2-DaMP

cytosol -
C’ GFP library on the background of CCT mutant

cytosol24.4010.939481No
